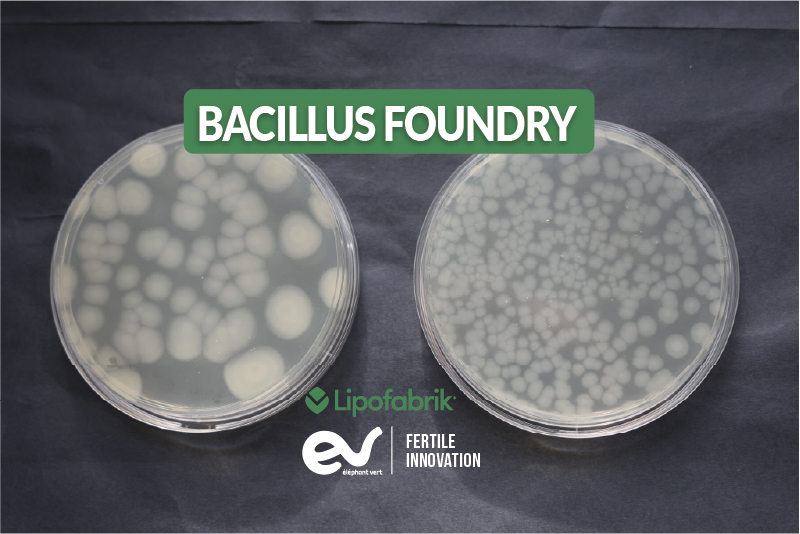

BACILLUS FOUNDRY, LipofabrikHEA’s microbial breakthrough platform shaping the future of sustainable agriculture
With the official establishment of the Bacillus Foundry, Lipofabrik—the R&D powerhouse of the Elephant Vert Group—is turning cuttingedge science into nextgeneration biosolutions ready for global markets. As climate change reshapes agriculture and environmental pressures intensify, this new platform positions the company at the forefront of innovation, delivering more resilient, sustainable and high-impact solutions for farmers worldwide.

Through Yazen Yaseen’s perspective, Head of R&D EV Group Department (LIPOFABRIK) discover how EV is charting a distinctive, expert‑driven path in biosolutions.
Inside the Bacilo Foundry: the three‑pillar platform driving faster, safer biosolutions
Lipofabrik has developed a unique innovation engine: the Bacilo Foundry. This platform was created to master microbial development and accelerate the delivery of high-performance, sustainable solutions. It is structured around three strategic pillars:
- Strain evaluation and selection
- Bioprocess development and optimization, i.e process intensification, and high-yield metabolite production, enabling efficient and scalable extraction at industrial level
- Risk mitigation linked to environmental variability as well as environmental risk assessments required for regulatory approval.
This integrated framework enables faster, safer, and more reliable product development from laboratory to field.
Solving real agronomic challenges: The Bacilo Foundry is the cornerstone of Eléphant Vert’s R&D Technology Platform, delivering high‑performance solutions
The Technology Platform ensures that new solutions directly address farmers’ real-world needs. The Bacilo Foundry is the engine, delivering the active substance for biosolutions, designed to deliver high and consistent efficacy – comparable or superior to chemical references – while remaining competitively priced and easy to use without operational constraints.
Product development follows a rigorous evaluation pipeline, beginning with in-vitro screening against target pathogens, followed by in-planta confirmation and multisite field trials conducted in partnership with growers. Farmer feedback is integrated throughout the development process to continuously improve efficiency, reliability, and ease of application.
In parallel, the platform investigates the modes of action of all solutions, whether targeting fungal, bacterial, or insect pathogens, or influencing plant physiology. This mechanistic understanding supports continuous innovation and product improvement.
Choosing Bacillus subtilis: The scientific, safe and high‑performance path to next‑gen biosolutions
Bacilo subtilis is one of the most extensively studied microorganisms and is widely recognized as a secondary metabolite factory (Trabelsi et al., 2021). It holds GRAS (Generally Recognized As Safe) status from the U.S. FDA, meaning it poses no risk to humans. Naturally found in soils, it interacts with plants and beneficial microbes, making it particularly relevant for agricultural applications.
With more than 5,000 genes, including 5,033 protein-coding sequences, B. subtilis produces numerous industrially relevant enzymes such as proteases, amylases, and cellulases (Sohail et al., 2025; Harwood et al., 2018). Approximately 5% of its genome is dedicated to secondary metabolite biosynthesis (Iqbal et al., 2023), generating non-ribosomal peptides, ribosomal peptides, polyketides, bacteriocins, and volatile molecules.
These metabolites exhibit strong biocontrol and biostimulant properties, positioning B. subtilis as a cornerstone for next generation biosolutions in agriculture, food safety, and biotechnology (Iqbal et al., 2023; Yaseen et al., 2017) as Bacilo-based products are increasingly recognized as sustainable alternatives to chemical inputs
Lipofabrik’s founders and team, both longstanding academic experts on B. subtilis and its metabolites, built on decades of research to create the Bacillus Foundry and transform this scientific expertise into practical and scalable solutions.

A smarter path to Biosolutions: extracting B. subtilis metabolites for consistent, high‑performance field results
A major challenge remains across the sector: ensuring the stability and performance of living microbes under real environmental conditions.
O Bacilo Foundry addresses this limitation by developing a new generation of biocontrol and biostimulant solutions centered on the extraction of key active metabolites produced by B. subtilis which could be one pure molecule or mix of molecules produced by the same strain. This approach ensures that biological activity is maintained even under demanding field conditions, while natural production processes are optimized to achieve industrial cost competitiveness. Today, the foundry has rapidly become a strategic pillar of our pipeline and R&D portfolio, serving as a key source of innovative product candidates in both biocontrol and biostimulation. Its first market‑launched innovation, NOVASTIM®, is a unique foliar biostimulant based on B. subtilis metabolites supernatant. Already available in numerous countries, it has demonstrated excellent performance across multiple dimensions, including harvest quality, flowering and fruiting, stress tolerance, and post‑harvest conservation
To strengthen long-term competitiveness, the innovation strategy includes systematic patent protection for future biocontrol products, securing strong intellectual property foundations for upcoming solutions.
Referências
Trabelsi, H., Dhali, D., Yaseen, Y., Leclère, V., Jacques, P., & Coutte, F. (2021). Bacillus subtilis-based microbial cell factories. HAL Open Science Archive.
Sohail, H., Naveed, M., Aziz, T., Mohamed, R. A. E. H., & AlJoufi, F. A. (2025).
Wholegenome analysis of Bacillus subtilis MBBL2: genomic characterization and comparative genomics. Functional & Integrative Genomics, 25, Article 167. [link.springer.com]
Harwood, C. R., Mouillon, JM., Pohl, S., & Arnau, J. (2018).
Secondary metabolite production and the safety of industrially important members of the Bacillus subtilis group. FEMS Microbiology Reviews, 42(6), 721–738. [academic.oup.com]
Iqbal, S., Begum, F., Rabaan, A. A., e outros. (2023).
Classification and multifaceted potential of secondary metabolites produced by the Bacilo subtilis group: A comprehensive review. Molecules, 28(3), 927.
[mdpi.com]
Yaseen, Y., Gancel, F., Béchet, M., Drider, D., & Jacques, P. (2017). Study of the correlation between fengycin promoter expression and its production by Bacillus subtilis under different culture conditions and the impact on surfactin production. Archives of Microbiology, 199, 1371–1382. [link.springer.com]